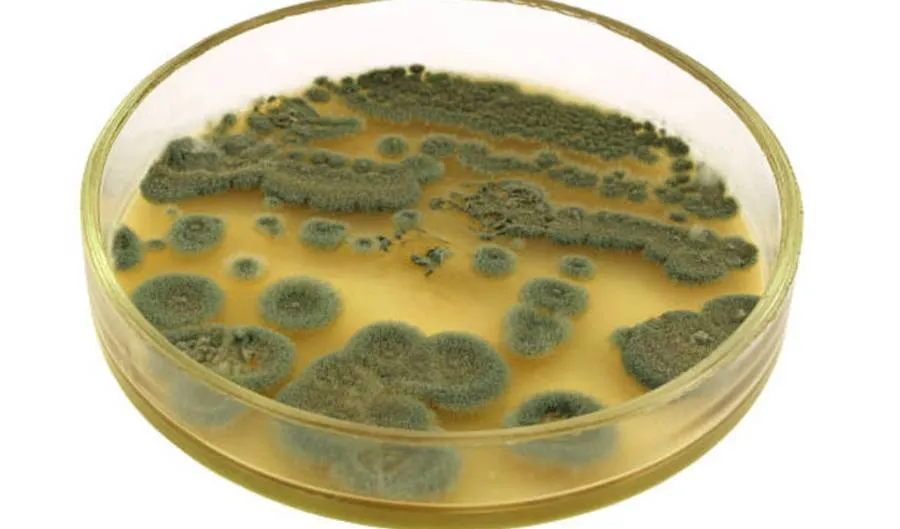
Penicillium

· Felipe Vengoechea
10 Ejemplos de Ascomicetos: De la Trufa Negra al Moho Tóxico
10 Ascomicetos impactantes: Trufas, Penicillium, Cordyceps y más. Descubre su rol en medicina, industria y naturaleza.

Pero quizás la contribución más importante de Penicillium a la humanidad es la penicilina, el primer antibiótico. La penicilina fue descubierta por Alexander Fleming en 1928, cuando observó que Penicillium notatum inhibía el crecimiento de bacterias en una placa de Petri. Esta observación llevó al desarrollo de los antibióticos, que han salvado innumerables vidas desde su introducción.
Aspergillus
El género Aspergillus es otro grupo de ascomicetos con una amplia gama de roles en la naturaleza y en la industria. Algunas especies de Aspergillus son utilizadas en la producción de alimentos fermentados, como el miso y la salsa de soja. Aspergillus niger, por ejemplo, es un componente clave en la producción de ácido cítrico, un aditivo alimentario común.
Sin embargo, no todas las especies de Aspergillus son beneficiosas. Algunas pueden ser patógenas, causando infecciones en humanos y animales. Aspergillus fumigatus, por ejemplo, puede causar aspergilosis, una enfermedad pulmonar que puede ser grave en personas con sistemas inmunológicos debilitados.

Estos son solo algunos ejemplos de la increíble diversidad y relevancia de los ascomicetos. A medida que continuamos explorando este fascinante grupo de hongos, seguramente descubriremos aún más sobre su biología y su papel en nuestro mundo. En las siguientes secciones, profundizaremos en la importancia de los ascomicetos en la naturaleza y la industria, su impacto en la salud humana, su modo de reproducción, su diversidad y distribución, su papel en la investigación científica, y los desafíos y oportunidades para su conservación.
Variedades de ascomicetos comunes
- Penicillium chrysogenum: Este es el hongo del que se aisló por primera vez la penicilina, el primer antibiótico. Se encuentra comúnmente en el aire y en el suelo.
- Candida albicans: Este hongo es un comensal común en la piel y las membranas mucosas de los humanos, pero puede causar infecciones oportunistas, especialmente en personas con sistemas inmunológicos debilitados.
- Aspergillus flavus: Este hongo es conocido por producir aflatoxinas, que son potentes carcinógenos. Puede contaminar cultivos como el maíz y los cacahuetes y causar enfermedades en humanos y animales si los alimentos contaminados son consumidos.
- Claviceps purpurea: Este hongo produce el cornezuelo del centeno, una enfermedad de las gramíneas. También produce alcaloides del cornezuelo, que pueden causar ergotismo en humanos y animales.
- Neurospora crassa: Este hongo es un organismo modelo en la genética y la biología celular. Fue fundamental en el desarrollo de la teoría “un gen-una enzima”.
- Peziza domiciliana: Conocido comúnmente como el hongo de la taza domiciliaria, este hongo se encuentra a menudo en interiores, especialmente en lugares húmedos como sótanos y baños.
- Tuber melanosporum: Este es el hongo que produce la preciada trufa negra. Las trufas son cuerpos fructíferos que crecen bajo tierra en simbiosis con las raíces de los árboles.
- Pseudogymnoascus destructans: Este hongo es el causante del síndrome de la nariz blanca, una enfermedad que ha diezmado las poblaciones de murciélagos en América del Norte.
- Xylaria polymorpha: Conocido comúnmente como el hongo de los muertos o el hongo de la vela, este hongo se encuentra comúnmente en madera muerta y produce cuerpos fructíferos alargados y oscuros que se asemejan a las astillas de madera quemada.
- Ophiostoma ulmi: Este hongo es el causante de la enfermedad del olmo holandés, que ha devastado las poblaciones de olmos en Europa y América del Norte. Se propaga a través de los escarabajos de la corteza del olmo.

Importancia de los Ascomicetos en la Naturaleza y la Industria
Los ascomicetos desempeñan un papel crucial en la naturaleza y en la industria. En la naturaleza, son descomponedores vitales, descomponiendo la materia orgánica muerta y reciclando nutrientes en el ecosistema. Algunos ascomicetos también forman relaciones simbióticas con plantas, ayudando a las plantas a absorber nutrientes del suelo. Estas relaciones, conocidas como micorrizas, son esenciales para el crecimiento y la salud de muchas plantas, incluyendo árboles forestales y cultivos agrícolas.
En la industria, los ascomicetos son utilizados en la producción de una variedad de productos. Como hemos mencionado, la levadura de panadería (Saccharomyces cerevisiae) se utiliza en la producción de pan, cerveza y vino, mientras que otras especies de ascomicetos se utilizan en la producción de quesos y otros alimentos fermentados. Algunos ascomicetos también son utilizados en la producción de medicamentos, como la penicilina, y en la producción de enzimas industriales.
Ascomicetos y la Salud Humana
Los ascomicetos tienen un impacto significativo en la salud humana, tanto positivo como negativo. Por un lado, algunos ascomicetos son beneficiosos para la salud humana. Como hemos mencionado, la penicilina, producida por el hongo Penicillium, fue el primer antibiótico y ha salvado innumerables vidas desde su descubrimiento. Otros ascomicetos producen compuestos con propiedades antivirales, anticancerígenas y antiinflamatorias, y son una fuente importante de nuevos medicamentos.
Por otro lado, algunos ascomicetos pueden ser perjudiciales para la salud humana. Algunos son patógenos que pueden causar infecciones en humanos, especialmente en personas con sistemas inmunológicos debilitados. Otros producen toxinas que pueden ser dañinas si se ingieren o se inhalan. Además, las esporas de algunos ascomicetos pueden causar alergias y asma.
Métodos de Reproducción de los Ascomicetos
Los ascomicetos se reproducen tanto sexual como asexualmente. La reproducción sexual se realiza a través de la formación de ascosporas en los ascos. Cada ascus generalmente contiene ocho ascosporas, que son liberadas cuando el ascus se rompe o se disuelve. Las ascosporas pueden ser llevadas por el viento, el agua o los animales a nuevos lugares, donde pueden germinar y formar una nueva colonia de hongos.
La reproducción asexual en los ascomicetos se realiza a través de la formación de conidiospores o esporas asexuales. Estas esporas se forman en estructuras especiales llamadas conidióforos y son liberadas en el ambiente. Al igual que las ascosporas, las conidiospores pueden ser llevadas a nuevos lugares, donde pueden germinar y formar una nueva colonia de hongos.
Diversidad y Distribución de los Ascomicetos
Los ascomicetos son un grupo extremadamente diverso de hongos, con más de 64,000 especies conocidas. Se encuentran en casi todos los ecosistemas del mundo, desde los desiertos hasta las selvas tropicales, y desde las montañas hasta los océanos. Algunos ascomicetos son terrestres, mientras que otros son acuáticos. Algunos prefieren ambientes cálidos, mientras que otros pueden sobrevivir en ambientes fríos y extremos.
La diversidad de formas y tamaños en los ascomicetos también es asombrosa. Algunos son microscópicos, mientras que otros forman cuerpos fructíferos grandes y visibles. Algunos ascomicetos son unicelulares, como las levaduras, mientras que otros forman redes complejas de hifas.
La diversidad de los ascomicetos no es estática, sino que continúa evolucionando. Los científicos están constantemente descubriendo nuevas especies de ascomicetos, y nuestra comprensión de la diversidad y la evolución de este grupo de hongos sigue creciendo.
Ascomicetos en la Investigación Científica
Los ascomicetos son un recurso valioso para la investigación científica. Como hemos mencionado, la levadura de panadería (Saccharomyces cerevisiae) es un organismo modelo en biología, utilizado para estudiar procesos biológicos fundamentales. Otros ascomicetos también son importantes en la investigación, incluyendo especies que son patógenos humanos o de plantas, o que producen compuestos bioactivos.
La investigación en ascomicetos puede tener aplicaciones prácticas en medicina, agricultura y biotecnología. Por ejemplo, el estudio de los ascomicetos patógenos puede llevar al desarrollo de nuevos tratamientos para las infecciones fúngicas. Del mismo modo, el estudio de los ascomicetos que forman micorrizas puede ayudar a mejorar la salud y la productividad de los cultivos agrícolas.

Amenazas y Conservación de los Ascomicetos
A pesar de su importancia, los ascomicetos enfrentan varias amenazas. La pérdida de hábitat, la contaminación y el cambio climático pueden tener un impacto negativo en la diversidad y la abundancia de los ascomicetos. Algunas especies de ascomicetos están en peligro de extinción y necesitan medidas de conservación.
La conservación de los ascomicetos no solo es importante para la supervivencia de estas especies, sino también para los ecosistemas que dependen de ellas. Como descomponedores, los ascomicetos juegan un papel crucial en los ciclos de nutrientes. Como simbiontes, ayudan a las plantas a absorber nutrientes del suelo. Y como productores de compuestos bioactivos, son una fuente importante de nuevos medicamentos.
El Papel de los Ascomicetos en el Mundo
Los ascomicetos son un grupo fascinante y diverso de hongos que desempeñan un papel crucial en la naturaleza y en la sociedad humana. Desde la producción de alimentos y medicamentos hasta la descomposición de la materia orgánica y la formación de relaciones simbióticas con las plantas, los ascomicetos están intrínsecamente vinculados a la vida en la Tierra.
A pesar de su importancia, todavía hay mucho que aprender sobre los ascomicetos. Cada nueva especie descubierta, cada nuevo compuesto bioactivo identificado, y cada nuevo mecanismo de interacción con las plantas o los animales que se descubre, nos recuerda cuán poco sabemos realmente sobre estos fascinantes organismos.
A medida que continuamos explorando el mundo de los ascomicetos, es esencial que también tomemos medidas para protegerlos. La conservación de los ascomicetos no solo es importante para la supervivencia de estas especies, sino también para la salud de nuestros ecosistemas y para nuestro propio bienestar.
En resumen, los ascomicetos son un testimonio de la increíble diversidad y complejidad de la vida en la Tierra. A través de su estudio, podemos obtener una visión más profunda de los procesos biológicos fundamentales, desarrollar nuevas herramientas y tratamientos para la medicina y la agricultura, y fomentar una mayor apreciación por la naturaleza y su conservación.
Referencias:
- Glass, N., & Donaldson, G. C. (1995). Development of primer sets designed for use with the PCR to amplify conserved genes from filamentous ascomycetes. Applied and Environmental Microbiology, 61(4), 1323-1330. Enlace al artículo
- Liu, Y. J., Whelen, S., & Hall, B. (1999). Phylogenetic relationships among ascomycetes: evidence from an RNA polymerse II subunit. Molecular Biology and Evolution, 16(12), 1799-1808. Enlace al artículo
- Toju, H., Tanabe, A. S., Yamamoto, S., & Sato, H. (2012). High-Coverage ITS Primers for the DNA-Based Identification of Ascomycetes and Basidiomycetes in Environmental Samples. PLoS ONE, 7(7), e40863. Enlace al artículo
- Degenkolb, T., & Vilcinskas, A. (2016). Metabolites from nematophagous fungi and nematicidal natural products from fungi as an alternative for biological control. Part I: metabolites from nematophagous ascomycetes. Applied Microbiology and Biotechnology, 100(9), 3799-3812. Enlace al artículo
- Encyclopaedia Britannica. (2023). Ascomycota. Recuperado de https://www.britannica.com/science/Ascomycota
- Gerkema, M. P., Davies, W. I. L., Foster, R. G., Menaker, M., & Hut, R. A. (2013). The nocturnal bottleneck and the evolution of activity patterns in mammals. Recuperado de https://www.ncbi.nlm.nih.gov/pmc/articles/PMC3712437/
- Glass, N. L., & Donaldson, G. C. (1995). Development of primer sets designed for use with the PCR to amplify conserved genes from filamentous ascomycetes. Applied and Environmental Microbiology, 61(4), 1323-1330. Recuperado de https://dx.doi.org/10.1128/aem.61.4.1323-1330.1995
- Liu, Y. J., Whelen, S., & Hall, B. D. (1999). Phylogenetic relationships among ascomycetes: evidence from an RNA polymerse II subunit. Molecular Biology and Evolution, 16(12), 1799-1808. Recuperado de https://dx.doi.org/10.1093/OXFORDJOURNALS.MOLBEV.A026092
- Toju, H., Tanabe, A. S., Yamamoto, S., & Sato, H. (2012). High-Coverage ITS Primers for the DNA-Based Identification of Ascomycetes and Basidiomycetes in Environmental Samples. PLoS ONE, 7(7), e40863. Recuperado de https://dx.doi.org/10.1371/journal.pone.0040863
- Degenkolb, T., & Vilcinskas, A. (2016). Metabolites from nematophagous fungi and nematicidal natural products from fungi as an alternative for biological control. Part I: metabolites from nematophagous ascomycetes. Applied Microbiology and Biotechnology, 100(9), 3799-3812. Recuperado de https://dx.doi.org/10.1007/s00253-015-7233-6



